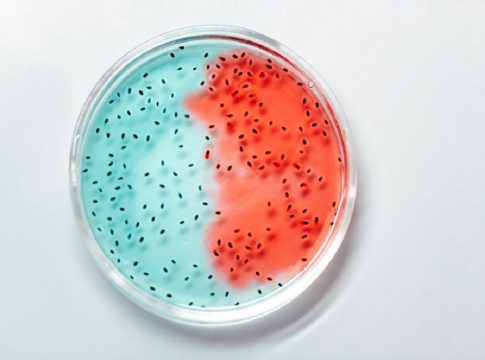

Gracias al avance de las nuevas tecnologías, ahora es posible conocer de una forma científica y cien por cien confiable, el potencial deportivo de los caballos de pura raza árabes, así como también el potencial de deportistas profesionales o amateurs, e incluso es factible conocer ciertas variantes genéticas del ganado, para aprovechar al máximo este recurso y optimizar el rendimiento. Todo ello es factible gracias a la investigación, desarrollo y tecnología de las pruebas genéticas, determinantes para evaluar predisposiciones y aptitudes físicas en cada uno de los casos, de manera que empresas como Sanbiotec, lo hacen posible.
Pruebas genéticas para caballos
Las pruebas genéticas para caballos son determinantes para evaluar la predisposición genética del animal y también las aptitudes físicas, con el fin de determinar el potencial deportivo de los caballos pura raza árabes. En vez de dejar el rendimiento de estos caballos al azar, ahora es posible comprobar el patrimonio genético del potro, y determinar si tiene o no, una predisposición genética para el galope.
En Sanbiotec han desarrollado el primer test genético capaz de estimar el potencial de esta raza de caballo, a través de un estudio minucioso de sus genes. Gracias a este test resulta mucho más fácil conocer si el potro cuenta con lo necesario para las carreras, lo que se traduce en un ahorro significativo de dinero, tiempo y esfuerzo, porque permite seleccionar solo los ejemplares que sí cuenten con ese potencial genético y deportivo.
A través de este exclusivo test genético, se pueden evaluar varios factores que pueden resultar determinantes en un caballo de pura raza árabe con potencial deportivo, como es el caso de: la masa muscular, el metabolismo energético aeróbico, la potencia, la fuerza, e incluso la capacidad de recuperación después de una sesión de entrenamiento.
En este sentido, es importante destacar que se ha demostrado la estrecha relación que existe entre la genética y la capacidad del caballo para ganar. Además, un caballo con potencial será mucho más fácil de entrenar y de llevar a los niveles deseados. Si bien, hay muchos otros factores que tienen un impacto directo en el rendimiento de un caballo, como la dieta, la morfología y el tipo de entrenamiento, se sabe que la genética tiene un impacto aproximadamente del 30%.
En el caso de los caballos, cuantas más variaciones genéticas tengan, más altas serán sus probabilidades de triunfo. Para ello, en el test genético se evalúan aspectos como el metabolismo oxidativo, la adaptación cardiovascular, el mantenimiento de la homeostasis y la contracción muscular.
Pruebas genéticas para ganado
Las pruebas genéticas para ganado también constituyen otro factor determinante para aumentar la productividad y calidad de los productos. Mejorar el rendimiento de la producción también es posible, al conocer las variantes genéticas de las caseínas de cada vaca. El conocimiento de ese valor se traduce en importantes ventajas, porque permite una mejor clasificación del producto en función de su calidad, y al mismo tiempo, mejorar el rendimiento de la producción.
¿Por qué es importante conocer el tipo de caseína? Porque dependiendo de ese resultado será factible obtener un producto de mayor calidad, enfocado en las necesidades del público en general. Un ejemplo de ello es la caseína beta tipo A2, la cual es la más recomendable para la elaboración de leche para bebés, así como para los adultos que presenten algún tipo de problema digestivo o intolerancia de los productos derivados de la leche; mientras que la caseína kappa tipo B, permite una solidificación mucho más rápida, por lo que es una excelente opción para la elaboración de quesos.
Es, justamente por lo anterior, que conocer el tipo de caseína predominante de un grupo de ganado permitirá aprovechar al máximo sus propiedades, optimizar la producción y desarrollar productos que cumplan con los más altos estándares de calidad. En este sentido, es importante destacar que la calidad de la leche se mide en función del porcentaje de grasa, así como también por el contenido de proteínas, y la caseína está presente en el 80% de esas proteínas totales.
Como comentamos anteriormente, existen varios tipos de caseína, y a su vez, cada uno de esos tipos tienen variantes genéticas, por lo que tienen propiedades y estructuras químicas completamente diferentes. Por eso, es recomendable conocerlas con exactitud, y así poder elevar la calidad de los productos en base al conocimiento genético y científico.
Pruebas genéticas para humanos
Otro de los servicios que proporciona Sanbiotec, son las pruebas genéticas para humanos, determinantes para conocer con más detalle la genética de los deportistas, sean estos profesionales o amateurs. ¿Por qué es importante? Porque este conocimiento permitirá abordar los entrenamientos, el rendimiento deportivo y las posibles lesiones, de forma más personalizada, y por ende, más efectiva, lo que tendrá un impacto directo en la recuperación y efectividad del deportista.
Esta prueba genética es sumamente sencilla y se puede obtener mucha información, con tan solo una prueba de saliva. De ese estudio genético será posible conocer con detalle, aspectos como la aptitud deportiva y el riesgo de lesiones.
Cada día son más los deportistas que recurren a este tipo de tecnología, y es que conocer la parte genética, entre otras cosas, les permite mejorar todo lo relacionado con la nutrición, entendiendo que cada cuerpo es diferente a los demás, lo que permite proporcionar al organismo lo que verdaderamente necesita para desarrollarse sano y fuerte. De igual forma, ese conocimiento también le permitirá al entrenador desarrollar una rutina personalizada, en función de los puntos más fuertes y las debilidades.
Adicionalmente, este estudio genético evalúa cinco marcadores, para determinar cuáles son los factores de riesgo de lesiones deportivas. Ese conocimiento constituye una herramienta de gran valor para la prevención, y en caso de lesión, para acelerar la recuperación.
El conocimiento genético, sin duda alguna, ofrece herramientas muy poderosas para mejorar el rendimiento deportivo, conocer el potencial de un caballo de pura raza árabe, e incluso para mejorar la productividad y calidad de los productos derivados del ganado. Por supuesto, para aprovechar todos los beneficios que proporciona esta información, es fundamental contar con especialistas en el área de investigación y desarrollo de biotecnología, como es el caso de Sanbiotec.